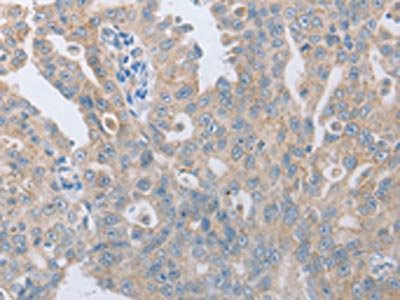

TACR2 Antibody
-
中文名稱:TACR2兔多克隆抗體
-
貨號:CSB-PA833308
-
規格:¥1100
-
圖片:
-
The image on the left is immunohistochemistry of paraffin-embedded Human ovarian cancer tissue using CSB-PA833308(TACR2 Antibody) at dilution 1/10, on the right is treated with synthetic peptide. (Original magnification: ×200)
-
The image on the left is immunohistochemistry of paraffin-embedded Human cervical cancer tissue using CSB-PA833308(TACR2 Antibody) at dilution 1/10, on the right is treated with synthetic peptide. (Original magnification: ×200)
-
Gel: 10%SDS-PAGE, Lysate: 40 μg, Lane: Human liver cancer tissue, Primary antibody: CSB-PA833308(TACR2 Antibody) at dilution 1/200, Secondary antibody: Goat anti rabbit IgG at 1/8000 dilution, Exposure time: 2 minutes
-
-
其他:
產品詳情
-
Uniprot No.:
-
基因名:
-
別名:TACR2; NK2R; NKNAR; TAC2R; Substance-K receptor; SKR; NK-2 receptor; NK-2R; Neurokinin A receptor; Tachykinin receptor 2
-
宿主:Rabbit
-
反應種屬:Human
-
免疫原:Synthetic peptide of Human TACR2
-
免疫原種屬:Homo sapiens (Human)
-
標記方式:Non-conjugated
-
抗體亞型:IgG
-
純化方式:Antigen affinity purification
-
濃度:It differs from different batches. Please contact us to confirm it.
-
保存緩沖液:-20°C, pH7.4 PBS, 0.05% NaN3, 40% Glycerol
-
產品提供形式:Liquid
-
應用范圍:ELISA,WB,IHC
-
推薦稀釋比:
Application Recommended Dilution ELISA 1:1000-1:2000 WB 1:200-1:1000 IHC 1:10-1:50 -
Protocols:
-
儲存條件:Upon receipt, store at -20°C or -80°C. Avoid repeated freeze.
-
貨期:Basically, we can dispatch the products out in 1-3 working days after receiving your orders. Delivery time maybe differs from different purchasing way or location, please kindly consult your local distributors for specific delivery time.
-
用途:For Research Use Only. Not for use in diagnostic or therapeutic procedures.
相關產品
靶點詳情
-
功能:This is a receptor for the tachykinin neuropeptide substance K (neurokinin A). It is associated with G proteins that activate a phosphatidylinositol-calcium second messenger system. The rank order of affinity of this receptor to tachykinins is: substance K > neuromedin-K > substance P.
-
基因功能參考文獻:
- This study revealed for the first time an increase of Mast Cells -nerve association and NK2R expression on Mast Cells during Allergic Rhinitis as well as nerve fibres containing receptors for mass cells. PMID: 28030866
- Neuropeptide signaling through neurokinin-1 and neurokinin-2 receptors augments antigen presentation by human dendritic cells PMID: 26371842
- The occurrence of a profound alteration in NK receptor expression in RMDD is a novel finding that suggests NK-1R and NK-2R pathways as possible players in major depressive disorder. PMID: 23142211
- NK2R-dependent neuropeptide signaling regulates Ag-specific T cell responses via activation of DC function PMID: 22474018
- This study demonistrated that no association of Tachykinin receptor 2 (TACR2) polymorphisms with Alzheimer's disease. PMID: 19375820
- Tachykinin NK2 receptors mediate smooth muscle contraction in human corpus cavernosum and spongiosum. PMID: 11906947
- Identification of a tachykinin NK(2) receptor splice variant. PMID: 12427486
- protease-activated receptor 2 agonists induced a contraction of murine intestinal smooth muscle that was mediated by nerves and requires both neurokinin 1 and 2 receptors PMID: 12801882
- NK2 receptors are compartmentalized at the plasma membrane PMID: 15294896
- We propose that the N-terminus of NKA is exposed and accessible to the extracellular medium. Subsequent amino acids of the NKA peptide become progressively more buried residues up to approximately one-third of the transmembrane-spanning domain. PMID: 17402972
- Data indicate that presynaptic and postsynaptic neuroneuronal and neuromuscular regulatory processes mediated by tachykinins via NK2r may occur for modulating human colonic motility. PMID: 17503489
- Increased proportion of alveolar macrophages expressing neurokinin 2 receptor may be involved in the pathogenesis of COPD. PMID: 17532769
- all three subtypes of NKRs are expressed in native human airway smooth muscle cells & IP3 levels are the primary mediators of NKR-stimulated initial [Ca2+]i increases, whereas store-operated Ca2+ channels mediate sustained phase of the [Ca2+]i increase. PMID: 18203813
- NK2 receptors are involved in the neuroneuronal and neuromuscular processes regulating human colonic motility. PMID: 18219665
- polymorphisms leading to the Ile23Thr and Arg375His amino acid exchanges are highly prevalent in the human TACR2 gene, but do affect the potency of the endogenous agonist NKA or small molecule antagonists with respect to intracellular Ca(2+) signalling PMID: 18601911
- The prevalence of the TACR2 mRNA alpha isoform strongly suggests a major involvement of tachykinin NK(2) receptor in the regulation of human colonic functions. PMID: 18835556
顯示更多
收起更多
-
亞細胞定位:Cell membrane; Multi-pass membrane protein.
-
蛋白家族:G-protein coupled receptor 1 family
-
數據庫鏈接:
Most popular with customers
-
-
YWHAB Recombinant Monoclonal Antibody
Applications: ELISA, WB, IHC, IF, FC
Species Reactivity: Human, Mouse, Rat
-
Phospho-YAP1 (S127) Recombinant Monoclonal Antibody
Applications: ELISA, WB, IHC
Species Reactivity: Human
-
-
-
-
-